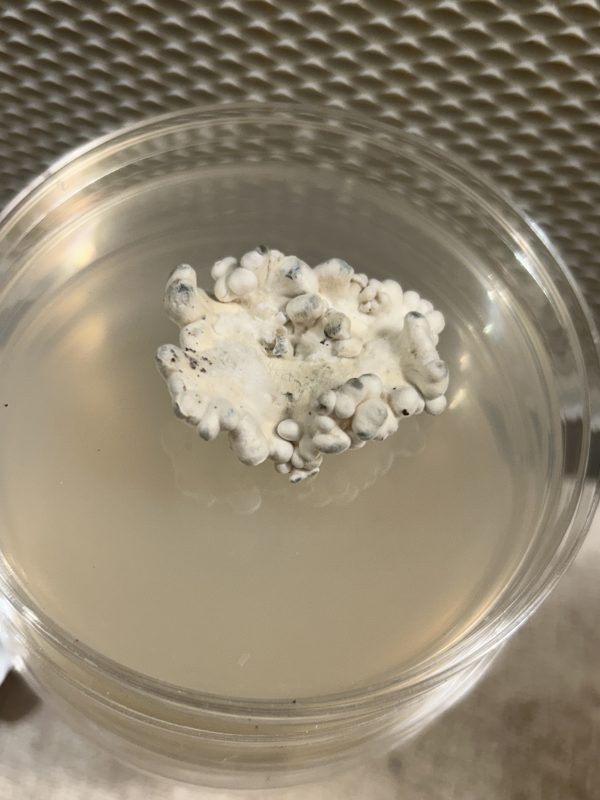

Enigma
€23.99
Why Liquid Culture Outperforms Spores: Liquid culture offers faster and more reliable germination compared to spores, with more consistent growth patterns and higher success rates. Ready-to-use cultures eliminate the waiting period typically required for germination and allow better control over strain genetics and characteristics, significantly reducing contamination risks.
Exceptional Purity and Quality Control: Our liquid cultures are produced under rigorous quality controls to maintain high concentrations and reliable integrity, delivering consistency and high standards with every product.
Isolated and Stable Varieties: Each culture is carefully isolated and genetically stabilized, ensuring consistent and repeatable results, which is why our products are trusted by dedicated researchers and enthusiasts.
Sterile and Long-Lasting: Packaged in sterile syringes for secure handling, our liquid cultures have an extended shelf life, often lasting over a year, compared to the typical three-month span of standard options.
Key Benefits:
✓ One 10ml syringe can inoculate 5+ bags
✓ 12+ months shelf life when properly stored
✓ Premium sterilized packaging
✓ Expert quality control
✓ Fast worldwide shipping
✓ Discreetly packaged
✓ Professional customer support
10ML High-Quality Liquid Culture
-
Description
-
Parameters
Origin:
Enigma is a remarkable and highly distinctive mutation of Psilocybe cubensis, first identified by cultivators who observed its unusual non-sporulating growth. This strain does not produce traditional mushroom caps; instead, it forms dense, brain-like clusters. Its discovery has sparked global interest, standing out as one of the most unique phenotypes in the mycological world.
Cultivation:
Enigma is prized for its unusually dense, compact growth, producing thick, convoluted masses rather than conventional fruiting bodies. Though it requires attentive environmental control, it rewards experienced cultivators with highly stable flushes. Due to its slower growth compared to standard P. cubensis strains, patience is essential, yet it consistently provides reliable yields once conditions are optimized.
Research Potential:
Enigma has drawn attention for research due to its exceptional morphology and alkaloid profile, which in some studies surpasses that of many traditional P. cubensis strains. Its lack of spore production challenges conventional cultivation methods and offers scientists a valuable subject for studying fungal mutations, genetic stability, and metabolite expression. Appearance: Rather than producing typical caps and stems, Enigma forms dense, coral- or brain-like clusters with intricate folds and a firm texture. The coloration ranges from creamy white to pale ivory, occasionally developing subtle bluish bruising under pressure. This alien-like growth habit makes it a fascinating specimen for display and research purposes.
Historical Significance:
First noted by underground cultivators, Enigma quickly captured the attention of the broader mycological community for its unprecedented form and genetics. Its emergence marked a pivotal moment in the understanding of how spontaneous mutations can shape fungal morphology and inspire further research into strain development and propagation techniques.
Note:
Enigma spores and culture samples are provided strictly for research, educational, and identification purposes. Ensure compliance with all applicable local laws and regulations before acquiring, cultivating, or handling this strain.
-
- Colonization Very Fast
-
-
- Harvest Very Big
-
-
- Resistance Big
-
-
- Strength Extremely strong
-
-
- Incubation 24-26 oC
-
-
- Fruiting 24-26oC
-
-
- Experience Begginer
-